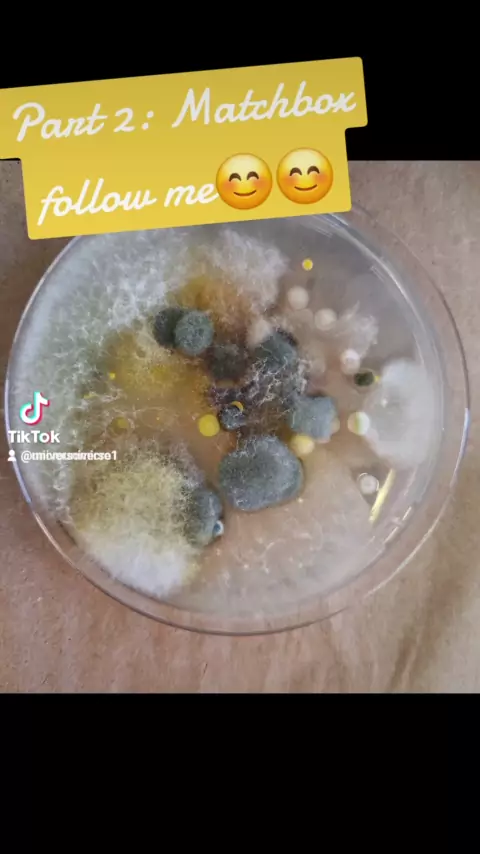

Follow
39
5
15
Achados!!
Reveal the invisible! Beyond its surface, our matchbox houses a hidden world of microorganisms. From bacteria to fungi, it's a reminder that life thrives in unexpected places. The world is not a sterile place, we are in contact with various microorganisms every day #part1 #part #fungi #bacteria #follow
More
Comment
Cancel
Send